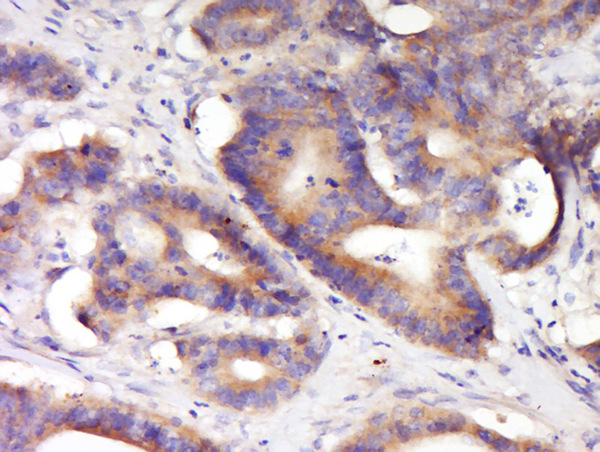

Immunohistochemical staining of human retina shows cytoplasmic positivity in photoreceptor cells.
Anti-KCNV2 Antibody
HPA031131
ApplicationsImmunoHistoChemistry
Product group Antibodies
ReactivityHuman
TargetKCNV2
Overview
- SupplierAtlas Antibodies
- Product NameAnti-KCNV2 Antibody
- Delivery Days Customer4
- ApplicationsImmunoHistoChemistry
- CertificationResearch Use Only
- ClonalityPolyclonal
- ConjugateUnconjugated
- Gene ID169522
- Target nameKCNV2
- Target descriptionpotassium voltage-gated channel modifier subfamily V member 2
- Target synonymsCDSRR, KV11.1, Kv8.2, RCD3B, potassium voltage-gated channel subfamily V member 2, potassium channel, subfamily V, member 2, potassium channel, voltage gated modifier subfamily V, member 2, voltage-gated potassium channel subunit Kv8.2
- HostRabbit
- IsotypeIgG
- Protein IDQ8TDN2
- Protein NamePotassium voltage-gated channel subfamily V member 2
- Scientific DescriptionRecombinant Protein Epitope Signature Tag (PrEST) antigen sequence
- ReactivityHuman
- Storage Instruction-20°C,2°C to 8°C
- UNSPSC41116161